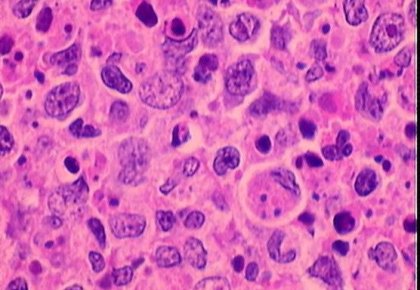

Infeccion Por Clamidia Causas Sintomas Y Tratamiento Dra Gomez Roig

Infeccion Por Clamidia

Infecciones Por Clamidia Sintomas Tratamiento Medlineplus En Espanol

Clamidia Que Es Y Que Provoca La Chlamydia Trachomatis

Clamidia Positiva Sintomas Causas Y Diagnostico Ingenes

Clamidias Y Otras Infecciones No Gonococicas Infecciones Manual Msd Version Para Publico General

Clamidia Sintomas Consecuencias Y Tratamiento Farma Sex

Clamidia Frecuente Silenciosa Y Peligrosa

Diagnostico Y Tratamiento De La Artritis Relacionada Con La Infeccion Por Clamidia Reumatologia Clinica English Edition

Enfermedades Transmision Sexual Clamidia Canalsalud

Alta Prevalencia De La Clamidia Genital En Adolescentes Gorgas La Prensa Panama

Clamidia Infeccion Sexual

Clamidia Una Enfermedad De Transmision Sexual Silenciosa Periodistas En Espanol

Que Es La Clamidia La Enfermedad Que Dana La Fertilidad En Hombres Tu Nota

La Clamidia Provoca Esterilidad Tambien En Los Hombres

Clamidia La Ets Que No Presenta Signos Muy Evidentes Mediquo

I Clamidia Salud Sexual Y Reproductivasdmr

Clamidia Una Infeccion De Transmision Sexual Silenciosa

Fundacion Piel Sana Noticia Que Es La Clamidia

Clamidia Enfermedades De Transmision Sexual

Clamidias Consultorio Todosida Accion De Prevencion Contra El Vih Sida Its

Clamidia Y Embarazo Todo Lo Que Debes Saber Sobre Esta Infeccion Madres Hoy

Clamidia Contagio Sintomas Tratamiento Y Prevencion Durex Espana

Clamidia Una Its Silenciosa Y Silenciada Clinica Buenavista

Https Encrypted Tbn0 Gstatic Com Images Q Tbn And9gcsmoerjyfoae8zgfaqy6b9j8l0nqvycmrbl3mkuphs Usqp Cau

La Primera Vacuna Contra La Clamidia

Infeccion Por Clamidia Que Es Y Como Afecta A Tu Salud

Clamidia Contagio Sintomas Tratamiento Y Prevencion Sico Mx

Infografia Clamidia La Enfermedad De Transmision Sexual Mas Comun En Mexico Ciencia Unam

Cientificos Argentinos Describen Como Una Proteina Favorece A La Clamidia Infobae

Chlamydia Fundacion Huesped

Clamidia La Its Que Es Mas Comun De Lo Que Parece Genioseguro

La Relacion Entre La Clamidia Y La Disfuncion Erectil

Que Sintomas Produce La Clamidia Y Como Prevenir Esta Enfermedad De Transmision Sexual El Diario Ny

Clamidia Archivos Bienestar Y Trascendencia

La Clamidia Infeccion Transmitida Sexualmente Artritis

Clamidia Sintomas Tratamiento Y Medicamentos

Vih E Infecciones De Transmision Sexual Its Osasun Eskola Osakidetza

Gonorrea Clamidia Y Sifilis El Preservativo Es Un Cortarrollos

Que Es La Clamidia Como Se Contrae Y Que Sintomas Tiene

El Increible Lugar Donde Prosperan Enormes Poblaciones De Clamidia

Clamidia Una Infeccion De Transmision Sexual Silenciosa

Clamidia Una Causa De Infertilidad

Clamidia Tracomatis Algunas Curiosidades Sobre Esta Enfermedad De Transmision Sexual Dr Felix Lugo

Chlamydia Fundacion Huesped

Como Saber Si Me Contagie De Clamidia

Clamidia Archivos Ceydes

Tests Para La Deteccion De Clamidia En La Farmacia

Infeccion Por Clamidia Clinica Belladona Gijon Y Aviles

Todo Lo Que Necesitas Saber Sobre Clamidia Fundacion Huesped

La Clamidia Es Una Enfermedad De Ginecologa Nogales Dra Bety Franco فيسبوك

Cuidado Clamidia Al Acecho Video

Clamidia Embarazo Babysitio

Aumentan Casos De Clamidia Gonorrea Y Sifilis En Estados Unidos

Los Menores De 25 Anos Padecen Dos Tercios De Los Casos De Infeccion Por Clamidia

Clamidia Salud Savia
Recomiendan Mas Pruebas Para La Clamidia

Todo Lo Que Debes Saber Sobre La Clamidia Youtube

Clamidia Vectores Libres De Derechos Istock

Clamidia Fundacion Huesped

Sifilis Gonorrea Y Clamidia La Sociedad Ya No Utiliza Preservativos

60 Ilustraciones Clipart Dibujos Animados E Iconos De Stock De Clamidia Getty Images

Chlamydia Trachomatis Y Su Relacion Con La Infertilidad Femenina Ivi Ge

La Infeccion Por Clamidia Incrementa El Riesgo De Infertilidad Ginefiv

3 Formas De Reconocer Los Sintomas De La Clamidia Para Mujeres

Clamidia Hd Stock Images Shutterstock

Https Www Sergas Es Saude Publica Folla Informativa Clamidia

Clamidia Estudian En Santa Fe Una Vacuna Contra Esta Bacteria Argentina Investiga

Clamidia Sintomas Complicaciones Y Tratamiento

Clamidia El Mal Venereo Mas Comun

145 Fotos E Imagenes De Clamidia Getty Images

Clamidia Causa Mas Frecuente De La Infertilidad Femenina Kienyke

Causas Y Tratamientos De La Clamidia Dr Marco Cosentino

Https Encrypted Tbn0 Gstatic Com Images Q Tbn And9gcq4tivip Mrtbufwe5tpv6yt98pyxhq4o Flirgap79joimxe2h Usqp Cau

Clamidia Hablemos De Sexo Y Amor

Clamidia En Hombres Sintomas Youtube

Gonorrea Y Clamidia Todo Lo Que Debes Saber Clinica Davila

Chile Mas De 300 000 Personas Tienen Clamidia Cluster Salud Americaeconomia

Clamidia Banco De Fotos E Imagenes De Stock Istock

Clamidia O Clamidiasis Enfermedades De Transmision Sexual Comunes

Clamidia Sintomas Y Tratamiento

Que Es La Clamidia Sintomas Y Tratamiento

La Clamidia Enfermedades De Transmision Sexual

Diagnostico De La Infeccion Por Clamidia

Infecciones Por Clamidia En Los Hombres

Clamidia Durante El Embarazo Todo Lo Que Debes Saber Mejor Con Salud

Nuevas Directrices Para Tratar Gonorrea Sifilis Y Clamidia Ante La Resistencia A Los Antibioticos

La Clamidia Concepto De Fondo Con Unas Lineas Suaves Suaves Fotos Retratos Imagenes Y Fotografia De Archivo Libres De Derecho Image 53782743

Gonorrea Sifilis Clamidia Que Sabes De Estas Enfermedades Sexuales Canarias7

Clamidias Imagina Mas

El Blog De Procrear La Clamidia Un Causante De Problemas De Fertilidad

Clamidia Sintomas Causas Y Como Tratar Esta Enfermedad De Transmision Sexual

Clamidia Mujer Sana

Detectan Un Gen Clave Que Permitiria A La Clamidia Permanecer En El Cuerpo Sin Ser Detectada Unciencia

Clamidia Vectores Libres De Derechos Istock